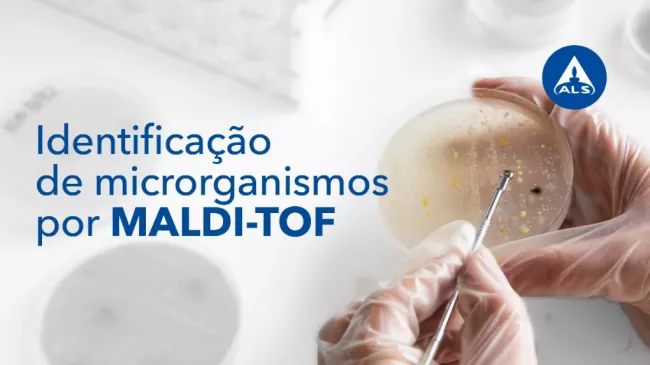

Teste com a ALS e melhore a qualidade dos seus produtos com o MALDI-TOF!
aposta em tecnologia de ponta e conta atualmente com a espectrometria de massa MALDI-TOF. Esta é uma técnica que identifica precisa e rapidamente microrganismos, e que se baseia na medição da massa molecular dos peptidos e proteínas presentes na amostra.
Melhore a performance dos seus animais com a ALS
Veja o artigo completo aqui
introduziu recentemente um serviço de sequenciação do microbioma intestinal, oferecendo aos produtores e veterinários uma solução completa para a obtenção de dados abrangentes com conhecimentos aprofundados sobre o microbioma intestinal animal.
Melhore a performance dos seus animais com a ALS
Veja o artigo completo aqui 

Microbioma intestinal na suinicultura | Melhore a performance dos seus animais com a ALS!
A importância do perfil do microbioma intestinal na suinicultura e a utilização de novas técnicas de sequenciação